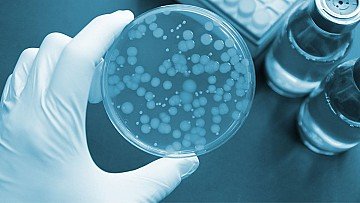
Press Release cover image

IBEC researcher Eduard Torrents has been awarded the ICREA Academia distinction by the Catalan Institute for Research and Advanced Studies (ICREA). The head of IBEC’s Bacterial Infections: Antimicrobial Therapies group received the award in the Life and Health Sciences category.
IBEC researcher Eduard Torrents Serra has been awarded the ICREA Academia Prize in the Life and Health Sciences category. The five-year grant will allow him to increase the impact and international projection of his research.
It is a great joy, as ICREA has valued the effort my research group and I have put into our work. They are equally deserving of this distinction.
Eduard Torrents
The ICREA Academia call for applications offers teachers in Catalan public universities a grant that allows them to increase their commitment to research by reducing their teaching obligations through financial support.
“The ICREA Academia award is a recognition of the work I have done so far and aims to allow university professors to focus on research. It is a great joy, as ICREA has valued the effort my research group and I have put into our work. They are equally deserving of this distinction.”, says Eduard Torrents.
Eduard Torrents leads the IBEC Bacterial Infections: Antimicrobial Therapies research group and is an Associate Professor at the Faculty of Biology of the University of Barcelona (UB). His research focuses on the study of new antimicrobial therapies and strategies to combat bacterial infections, with particular emphasis on multidrug-resistant bacteria and biofilms.
The ICREA Academia programme is an initiative to retain research talent in Catalonia. The grants, awarded by the Catalan Institute for Research and Advanced Studies (ICREA, for its acronym in Catalan), recognise the research career of academics working at one of Catalonia’s public universities who are in a fully active and expanding phase of their research activity. A total of 50 experts from different fields of knowledge have been awarded in this sixteenth edition.